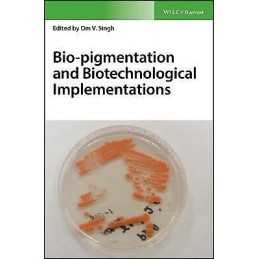
Bio-pigmentation and Biotechnological Implementations - 9781119166146

Environment and Climate-smart Food Production - 9783030715700
Nauja: Nauja, neskaityta, nenaudota idealios būklės knyga, be trūkusių ar pažeistų puslapių. Žiūrėti ... Skaityti daugiau apie būklęNauja: Nauja, neskaityta, nenaudota puikios būklės knyga, be trūkusių ar pažeistų puslapių. Išsamią informaciją rasite pardavėjo sąraše. Peržiūrėti visus sąlygų apibrėžimus atsidaro naujame lange arba skirtuke
270,01 €